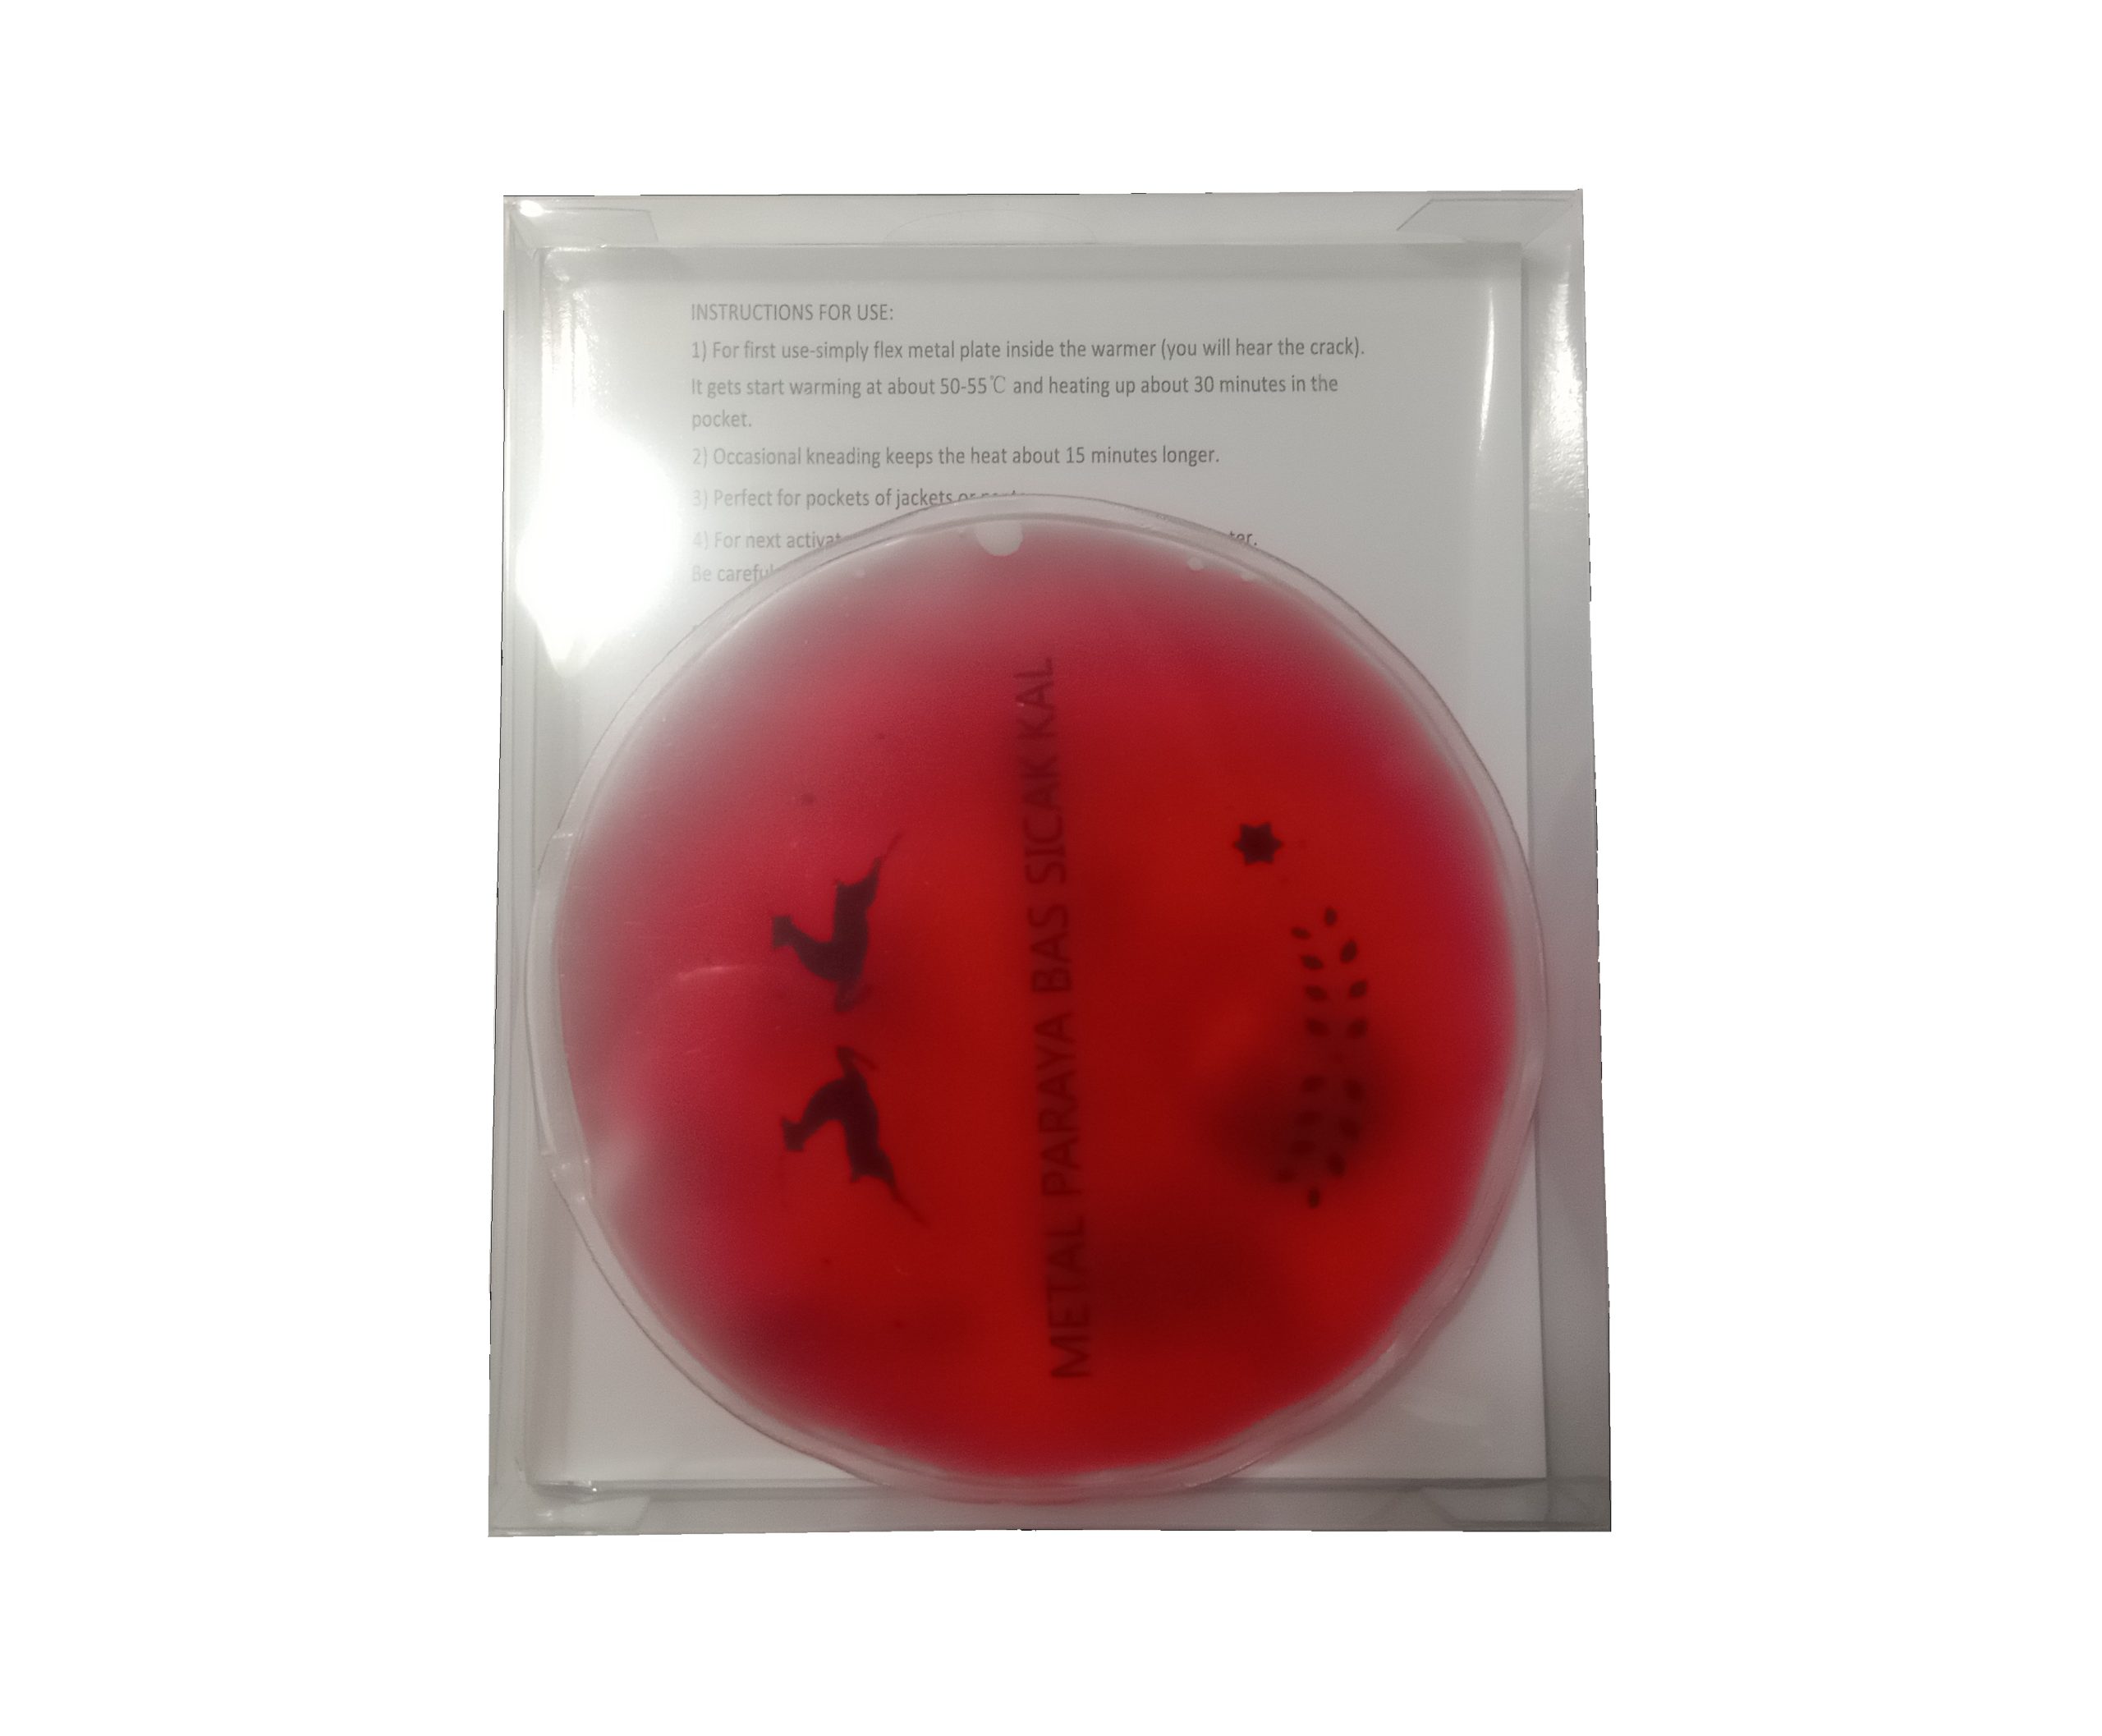

KIRMIZI CEYLAN CEP SOBASI,EL ISITICI,SICAK SU TORBASI PVC 9cm
| Kullanım Şekli:Paketin içindeki meta parayı elinizle çıtlatın. Metal çip katalizör görevi görmektedir, sonrasında jel katılaşacaktır. Sıcaklığı 30-40 dk sonunda yavaş yavaş azalacaktır.Tamamen soğutulduğunda, tüm kristaller jel halini alana kadar (5-10 dk) kaynar suda ısıtınız. Herhangi bir kesilme veya yırtılma olmadığı, çip kırılmadığı sürece ısıtıcıyı tekrar tekrar kullanabilirsiniz.Nasıl Çalışıyor? Jelin içindeki metali çıtlatıyorsunuz. Metal çipimiz Katalizör görevi görmekte. Tepkime sonucunda Sıvı Sodyum Asetat tuzu, katı hale geçiyor ve bu faz değiştirme esnasında dışarıya ısı veriyor, bu ısı 50 Dereceye kadar çıkıyor ve 30-45 dk süresince tepkime devam ediyor. Daha sonra, katı halde soğumuş i Isıtıcıyı, kaynatarak, tekrar Jel haline geçmesini ve potansiyel bir ısı kaynağı olmasını sağlıyoruz. |
SKU:
HT-RWB
Category: Hot Water Bottles and Hand Warmers
Description
| BOSPHORUS JEL EL ISITICI Evde, sokakta, konserde, maçta, işe giderken, kampta..Soguk havalarda ellerinizi ısıtmak artık cok kolay. Ağrıyan veya üşüyen ellerinize sıcak pres yapar.Kullanırken Dikkat Edilmesi Gerekenler: Ürünü kullanmanızın ardından tekrar kaynatarak sıvı hale getirebilir ve tekrar kullanabilirsiniz. Ürünü kullanımınızın ardından kaynatarak sıvı hale getiebilir ve tekrar kullanabilirsiniz.Ancak kaynattıktan sonra ürün soğumadan metal parayı çıtlatmayınız. |
Reviews (0)
Be the first to review “KIRMIZI CEYLAN CEP SOBASI,EL ISITICI,SICAK SU TORBASI PVC 9cm” Cancel reply
About brand
SİA bir Bosphorus markasidir.
Shipping & Delivery

Reviews
There are no reviews yet.